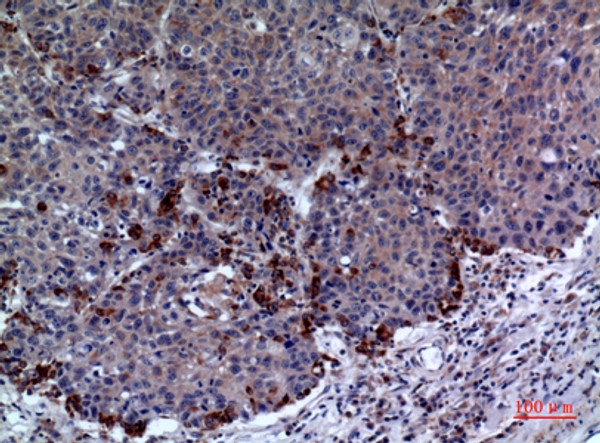
Immunohistochemical analysis of paraffin-embedded human-lung, antibody was diluted at 1:100

| Function | Thiol-specific peroxidase that catalyzes the reduction of hydrogen peroxide and organic hydroperoxides to water and alcohols, respectively. Plays a role in cell protection against oxidative stress by detoxifying peroxides and as sensor of hydrogen peroxide-mediated signaling events. Might participate in the signaling cascades of growth factors and tumor necrosis factor-alpha by regulating the intracellular concentrations of H(2)O(2). Reduces an intramolecular disulfide bond in GDPD5 that gates the ability to GDPD5 to drive postmitotic motor neuron differentiation. |
| Protein Name | Peroxiredoxin-1Natural Killer Cell-Enhancing Factor ANkef-AProliferation-Associated Gene ProteinPagThioredoxin Peroxidase 2Thioredoxin-Dependent Peroxide Reductase 2Thioredoxin-Dependent Peroxiredoxin 1 |
| Database Links | Reactome: R-HSA-3299685Reactome: R-HSA-5628897Reactome: R-HSA-8862803Reactome: R-HSA-9818027 |
| Cellular Localisation | CytoplasmMelanosomeIdentified By Mass Spectrometry In Melanosome Fractions From Stage I To Stage Iv |
| Alternative Antibody Names | Anti-Peroxiredoxin-1 antibodyAnti-Natural Killer Cell-Enhancing Factor A antibodyAnti-Nkef-A antibodyAnti-Proliferation-Associated Gene Protein antibodyAnti-Pag antibodyAnti-Thioredoxin Peroxidase 2 antibodyAnti-Thioredoxin-Dependent Peroxide Reductase 2 antibodyAnti-Thioredoxin-Dependent Peroxiredoxin 1 antibodyAnti-PRDX1 antibodyAnti-PAGA antibodyAnti-PAGB antibodyAnti-TDPX2 antibody |
Information sourced from Uniprot.org